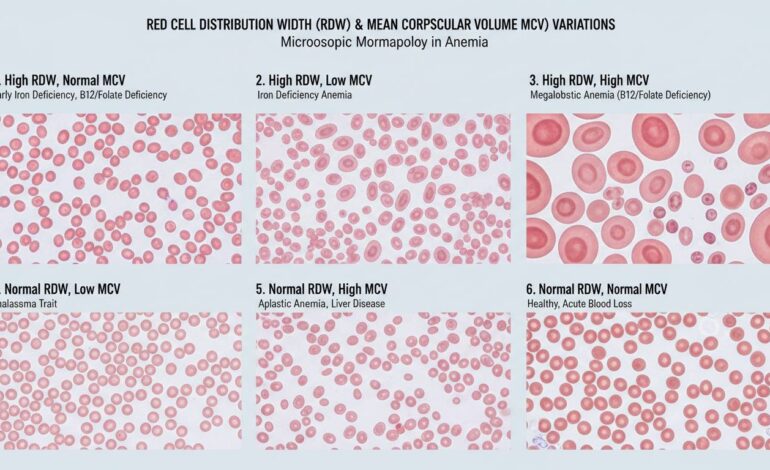
RDW Blood Test: What It Means, Normal Range, and Results Explained

RDW Blood Test: What It Means, Normal Range, and Results Explained
The RDW (Red Cell Distribution Width) blood test measures the variation in size among red blood cells. A higher RDW indicates greater size variability and can point to conditions like anemia or nutrient deficiencies. It’s often part of a complete blood count (CBC) and helps doctors interpret overall red cell health.
Understanding RDW: Why It Matters
At its core, RDW tells us how diverse our red blood cells are in size. If one day your cells are uniform, and the next, super varied—it can hint at underlying issues. Think of it as a snapshot of your body’s ability to produce consistent, healthy blood cells. When the range is wider, it could signal that something isn’t balanced—maybe iron’s low, maybe your body isn’t absorbing nutrients, or maybe an illness skews production.
RDW is practical. In routine checkups, if it’s out of range, clinicians dig deeper. It’s like the first alarm bell that says, “Check the iron, B12, or look for chronic disease.” On the other hand, a normal RDW doesn’t guarantee everything’s perfect, but it’s reassuring.
How RDW Is Calculated and Displayed
RDW is calculated by dividing the standard deviation of red cell volume by the mean cell volume (MCV), then multiplied by 100 to give a percentage. But honestly, most of us can ignore the formula—just know it reflects how much cell sizes vary. The lab shows it as a percentage with two decimal places, like 13.2%.
In practice, variations above or below the average range become red flags. Clinicians compare RDW with other CBC measures—MCV, hemoglobin (Hb), hematocrit (Hct)—to narrow down causes of irregularities.
Normal Range: What’s Typical for RDW?
Most labs consider a normal RDW range somewhere around 11.0% to 15.0%. But here’s the catch: these numbers vary slightly between labs depending on equipment and population norms. Reference ranges might even go up to 14.5% or as low as 10.8%. So, it’s best to interpret RDW results in the context of your lab’s reference values.
If your RDW is within that middle band? Good—most red cell populations are uniform. But push above it by even a point or two? That prompts more questions—even if hemoglobin and other results look okay.
Interpreting High RDW: What Could Be Going On
When RDW rises, it’s a clue, not a diagnosis. Here’s what a high RDW might suggest:
Iron-Deficiency Anemia
Often the top suspect. As your body runs low on iron, it releases older, smaller red cells along with newer, bigger ones—boosting size variability and raising RDW.
Vitamin B12 or Folate Deficiency
These cause fewer but larger red cells. When mixed with normal-sized cells, RDW spikes. It’s classic in megaloblastic anemia.
Hemolysis or Blood Loss
When you lose red cells quickly—due to bleeding or early destruction—the body churns out immature, larger cells to catch up. That mix pushes up RDW.
Chronic Conditions or Kidney Disease
Long-term illnesses or kidney issues can disrupt red cell production, creating inconsistency in cell sizes. RDW can be subtly elevated even before other signs emerge.
Mixed Anemia Types
If you’re low in iron and B12, your cells get all over the map. That jumble really hikes RDW.
“RDW is like a window into varied red cell production. It’s sensitive to shifts even before hemoglobin drops, making it a useful early warning sign,” says Dr. Sandra Lee, a hematologist with years of lab experience.
When RDW Is Low
Low RDW is rare and usually not a concern. It means most cells are pretty much the same size. That’s normally fine—red cells are just consistent.
Sometimes, however, overly uniform red cells could hint at lab error or contamination. But generally, low RDW isn’t flagged—it just doesn’t pop as interesting.
RDW and MCV: A Powerful Pair
Interpreting RDW alongside Mean Cell Volume (MCV) is more insightful than looking at RDW alone:
- High RDW + Low MCV: Points to iron deficiency. Small cells vary widely in size.
- High RDW + High MCV: Suggests B12 or folate deficiency—or mixed deficiency.
- Normal RDW + Low MCV: Mild iron deficiency or thalassemia trait perhaps.
- Normal RDW + High MCV: Could be due to liver disease or certain medications affecting cell growth.
This combination helps narrow down many confusing possibilities quickly.
Real-World Example: A Mini Case Study
Imagine a 45-year-old woman, feeling tired and light-headed. Her CBC shows:
- Hemoglobin: 11.2 g/dL (slightly low)
- MCV: 78 fL (lower than normal)
- RDW: 16.2% (above the lab reference of 11–15%)
This pattern—low hemoglobin, low MCV, and high RDW—leans heavily toward iron-deficiency anemia. The elevated RDW pushes you to test ferritin and iron levels next. Sure enough, ferritin is low, confirming the diagnosis.
Alternatively, if RDW were high with a high MCV? You’d head toward B12 or folate assessment instead.
Factors That Can Skew RDW Results
A couple of things may throw your RDW off even when there’s no real health issue:
- Recent transfusions: Mixing donor cells with your own shifts the size distribution quickly.
- Lab variation: Calibrations, sample handling, different machines—yes, they matter. Always compare with the lab’s own normal range.
- Recent pregnancy: Hormonal shifts and blood volume expansion can cause transient RDW changes.
So RDW doesn’t stand alone—it needs context and sometimes, a second look.
RDW’s Role in Modern Healthcare
RDW is affordable and widely available—it’s part of nearly every CBC worldwide. But its import goes beyond routine wellness checks. Recent studies suggest rising RDW can predict risks in cardiovascular and inflammatory diseases, even before standard markers raise alarm. Some cardiologists look at gradually increasing RDW as a subtle sign of systemic stress.
And because it’s cost-effective, it’s often used in screening older adults or people with chronic illnesses to flag emerging issues.
Improving RDW Through Lifestyle and Nutrition
If your RDW is elevated due to deficiencies, here’s how typical recovery might go:
- Iron-deficiency: Supplementing iron, along with a diet rich in leafy greens, red meat, or legumes, can improve cell uniformity. RDW should gradually normalize.
- B12 or folate deficiency: Take supplements or adjust diet. Folate-rich foods include citrus fruits and beans; B12 is abundant in animal products or fortified cereals.
- Chronic disease support: Treating the underlying condition (like kidney disease or inflammation) often brings RDW back into normal range as red cell production stabilizes.
Patience is key—normalization can take weeks as new red cells enter circulation.
Quick Table: RDW Interpretation Cheat Sheet
| RDW + MCV Pattern | Likely Cause | Next Steps |
|——————————-|—————————————-|—————————————-|
| High RDW + Low MCV | Iron-deficiency | Check ferritin, iron, TIBC |
| High RDW + High MCV | B12 or folate deficiency, mixed anemia | Test B12, folate, homocysteine |
| High RDW + Normal MCV | Early deficiency or mixed cause | Broad nutrient and chronic disease panel |
| Normal RDW + Abnormal MCV | Genetic traits or mild disturbances | Targeted testing based on suspicion |
| Low RDW + Normal MCV | Generally benign | No further action unless symptomatic |
How Often Should RDW Be Checked?
For most people, RDW is checked annually as part of regular wellness CBC panels. If your RDW was abnormal, doctors often re-test in 4–8 weeks after starting treatment to track trends.
When managing known deficiencies or chronic conditions, more frequent checks might help gauge therapy effectiveness. Still, over-testing adds unnecessary anxiety—restoring your red cell range is a gradual process.
What Patients Should Know (And Ask Their Doctors)
Many people glance at RDW and shrug, but here’s what to note:
- Ask if your lab’s “normal range” differs from textbooks.
- If RDW is high, request ferritin, B12, and folate tests.
- If you’re already on supplements or iron, don’t expect instant change; cell turnover is slow.
- Always interpret RDW with MCV, hemoglobin, and clinical context—not just the number.
Knowing what the test suggests helps you take charge of follow-ups and treatments.
Technological Advances around RDW
Lab machines used for CBCs now produce RDW with better precision. Some centers even report RDW-SD (standard deviation) along with RDW-CV (coefficient of variation). RDW-SD is measured in femtoliters and sometimes gives a clearer picture when MCV is normal.
On the research side, RDW’s being explored as a predictive marker in heart failure, diabetes, and even COVID-19 outcomes. While these applications aren’t routine yet, they hint at future broader uses.
When to See a Specialist
High RDW alone isn’t cause for alarm—but if it stays elevated despite correcting deficiencies, further evaluation may be wise. Hematology referral helps detect rare causes like bone marrow disorders or early myelodysplasia.
If your symptoms persist—fatigue, breathlessness, or pallor—alongside a consistently raised RDW, make that call. Early intervention often eases outcomes.
Common Misconceptions About RDW
Let’s clear up a few misunderstandings:
- “Low RDW is dangerous.” Not at all. It just means uniform cell size—usually fine.
- “RDW alone diagnoses anemia type.” Nope. It narrows possibilities but needs complementary tests.
- “High RDW always means anemia.” Actually some chronic diseases or inflammation may subtly raise RDW without anemia.
Misreading RDW can lead to wasted tests or unnecessary worry. Focus on trends, not a single number.
Summary and Next Steps
RDW reveals how consistent your red blood cells are in size. Normal ranges fall around 11–15%, but labs vary. When RDW is high, it tips you toward nutrient deficiencies, blood loss, or chronic issues. But always pair it with MCV and other CBC markers for clarity.
Practically, elevated RDW often means checking iron, B12, folate—and revisiting after supplementation. It’s a cost-effective early warning sign that supports prompt diagnosis and treatment.
In the future, RDW may gain traction as a risk marker in broader diseases. But for now, it remains a trusted ally in everyday blood work—simple, pragmatic, and surprisingly informative.
FAQs
What is a good RDW value?
Most labs consider RDW between 11.0% and 15.0% as normal. Exact range varies by lab, so always check your report’s reference values.
Can RDW be high with normal hemoglobin?
Yes, it can. High RDW with normal hemoglobin may signal early nutrient deficiencies or mixed conditions before anemia develops.
Does pregnancy affect RDW?
Pregnancy can cause temporary shifts in red cell size due to hormonal and blood volume changes, mildly altering RDW until things adjust.
How long does RDW take to normalize?
It depends on treatment and turnover, but you might see improvement in 4 to 8 weeks after correcting deficiencies with supplements or diet.
Is RDW a test I need to worry about?
Not really. RDW is part of routine CBC panels and flagged only if it’s abnormal. It’s more a guide than a cause for alarm—let your doctor interpret it in context.
In the end, RDW is a small number with big implications. Whether you’re tracking anemia, checking supplements, or just curious—knowing what that percentage means gives you power in your health journey.








